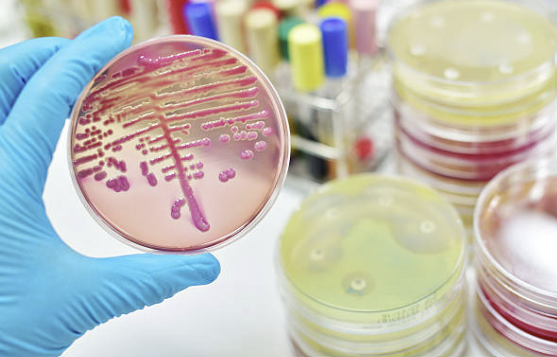

멜릭서 립밤 웜톤 쿨톤 발색리뷰
2024.12.23

안녕하세요 뷰티이야기하는 쏘블리입니다. 요즘 입술이 너무 건조해서 저도 모르게 입술에 계속 침을 바르...
출처
https://blog.naver.com/soy7752/223064798422
이슈모어 핫이슈
-
 강미나 근황 공개되자 반응 터졌다 기리고 화보 이후 분위기 완전히 달라진 이유
강미나 근황이 공개되자 온라인 반응이 빠르게 이어지고 있다. 최근 공개된 데뷔 10주년 프로필 촬영 사진과 …
강미나 근황 공개되자 반응 터졌다 기리고 화보 이후 분위기 완전히 달라진 이유
강미나 근황이 공개되자 온라인 반응이 빠르게 이어지고 있다. 최근 공개된 데뷔 10주년 프로필 촬영 사진과 …
-
 문상민 재계약 1년 먼저 끝냈다 어썸과 다시 짠 장기 플랜
문상민 재계약 소식이 전해지며 배우 문상민의 다음 행보에 관심이 쏠리고 있다. 기존 전속계약 만료까지 1년 …
문상민 재계약 1년 먼저 끝냈다 어썸과 다시 짠 장기 플랜
문상민 재계약 소식이 전해지며 배우 문상민의 다음 행보에 관심이 쏠리고 있다. 기존 전속계약 만료까지 1년 …
-
 이민기 추징금 납부까지 마쳤다 차분히 입장 밝힌 뒤 더 주목받은 차기작
이민기 세무조사 관련 공식 입장이 공개된 이후 배우 이민기의 차분한 대응 방식에 관심이 이어지고 있다. 최근…
이민기 추징금 납부까지 마쳤다 차분히 입장 밝힌 뒤 더 주목받은 차기작
이민기 세무조사 관련 공식 입장이 공개된 이후 배우 이민기의 차분한 대응 방식에 관심이 이어지고 있다. 최근…
관련 포스팅
Copyright blog.dowoo.me All right reserved.